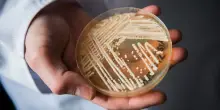

s

Cronaca
Candida auris: un fungo pericoloso per la salute pubblica
11-09-2025, 16:55
Candida auris rappresenta un pericolo crescente per i pazienti negli ospedali europei, con una resistenza preoccupante ai trattamenti. Leggi tutto Candida auris: un fungo pericoloso per la salute pubblica su Notizie.it.
CONTINUA A LEGGERE

22

0

0